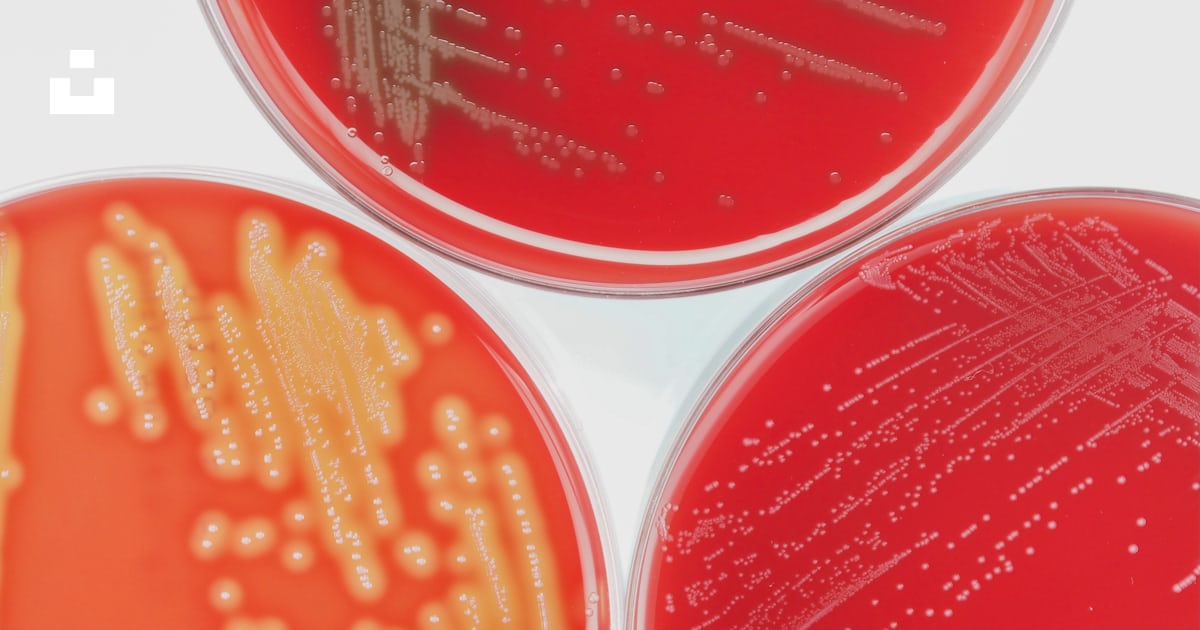
Un gros plan de trois cercles rouges et jaunes photo – Image gratuite ...

3 Cercles Rouges
Explore the stunning energy of urban 3 Cercles Rouges with hundreds of dynamic images. highlighting the diversity of photography, images, and pictures in urban settings. designed to showcase urban culture and lifestyle. Browse our premium 3 Cercles Rouges gallery featuring professionally curated photographs. Suitable for various applications including web design, social media, personal projects, and digital content creation All 3 Cercles Rouges images are available in high resolution with professional-grade quality, optimized for both digital and print applications, and include comprehensive metadata for easy organization and usage. Our 3 Cercles Rouges gallery offers diverse visual resources to bring your ideas to life. Each image in our 3 Cercles Rouges gallery undergoes rigorous quality assessment before inclusion. Our 3 Cercles Rouges database continuously expands with fresh, relevant content from skilled photographers. The 3 Cercles Rouges archive serves professionals, educators, and creatives across diverse industries. Whether for commercial projects or personal use, our 3 Cercles Rouges collection delivers consistent excellence. Cost-effective licensing makes professional 3 Cercles Rouges photography accessible to all budgets. Multiple resolution options ensure optimal performance across different platforms and applications. Comprehensive tagging systems facilitate quick discovery of relevant 3 Cercles Rouges content. Diverse style options within the 3 Cercles Rouges collection suit various aesthetic preferences. Regular updates keep the 3 Cercles Rouges collection current with contemporary trends and styles.



















/posters-cercles-rouges.jpg.jpg)

/stickers-cercle-rouge-peint.jpg.jpg)




















